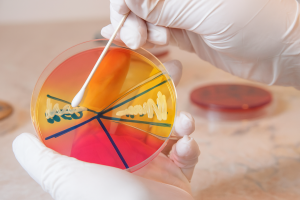

Agar Baird-Parker: El estándar de oro para la detección de Staphylococcus aureus bajo la norma ISO 6888
El control y detección de Staphylococcus aureus es un componente crítico en los programas de inocuidad alimentaria debido a su capacidad para producir enterotoxinas termoestables que pueden causar intoxicaciones graves incluso cuando la bacteria ya no está presente. Para su detección y enumeración, la norma ISO 6888 continúa siendo el método de referencia internacional, proporcionando un enfoque estandarizado y altamente confiable.
Dentro de este método, el Agar Baird-Parker (BP) destaca como el medio selectivo y diferencial más utilizado y validado para el aislamiento presuntivo de S. aureus, gracias a su composición específica que favorece el crecimiento del patógeno mientras suprime la microbiota acompañante.
✅ Importancia de controlar Staphylococcus aureus en alimentos
- Riesgo toxicológico crítico. S. aureus puede producir enterotoxinas estafilocócicas (EE), responsables de intoxicaciones alimentarias de rápida aparición (1–6 horas), caracterizadas por vómito, náuseas y dolor abdominal.Estas toxinas son resistentes al calor, por lo que pueden sobrevivir incluso después de la cocción.
- Amplia distribución en la cadena alimentaria. El microorganismo está presente en piel, mucosas y manos del personal, lo que lo convierte en un indicador directo de deficiencias en buenas prácticas de manipulación e higiene.
- Vulnerabilidad de ciertos alimentos. Los alimentos con alto contenido proteico y manipulación extensa —como lácteos, cárnicos, panadería rellena, pastelería y alimentos preparados— son especialmente susceptibles.
- Exigencia regulatoria internacional. Los límites microbiológicos para S. aureus están presentes en normativas globales, por lo que cumplir con ISO 6888 facilita auditorías, exportaciones y certificaciones.

✅ Agar Baird-Parker: Principios microbiológicos
El Agar Baird-Parker combina agentes selectivos y diferenciales que permiten identificar S. aureus con un alto nivel de certeza presuntiva:
🔹 Selectividad
- Telurito de potasio y cloruro de litio inhiben la mayoría de las bacterias acompañantes.
- Favorece el crecimiento de estafilococos tolerantes.
🔹 Diferenciación característica
S. aureus desarrolla colonias típicas gracias a dos reacciones clave:
- Reducción del telurito
Produce colonias negras o gris oscuras con brillo característico. - Actividad de la lecitinasa
La presencia de yema de huevo genera un halo opaco y nacarado alrededor de la colonia por la hidrólisis de lecitina.
Estas características permiten la lectura clara, aun en matrices complejas.
✅ El método ISO 6888 paso a paso
La norma ISO 6888 se compone de tres partes, aplicables según matriz y necesidad analítica:
- ISO 6888-1: Método con placa Baird-Parker + confirmación coagulasa.
- ISO 6888-2: Método con agar RPF; alternativa válida.
- ISO 6888-3: Método de prueba MPN para matrices especiales.
El procedimiento clásico con Agar Baird-Parker incluye:
- Preparación homogénea de la muestra.
- Siembra en superficie o profundidad según recuento esperado.
- Incubación a 35–37 °C por 24–48 h.
- Selección de colonias típicas (negras, brillantes, halo de opacidad).
- Confirmación mediante:
- Prueba de coagulasa (criterio clave).
- En ocasiones DNasa o manitol.
Los resultados se expresan como UFC/g o UFC/mL, de acuerdo con límites regulados para cada tipo de alimento.
✅ Relevancia para la industria alimentaria
El uso del Agar Baird-Parker bajo ISO 6888 permite:
✅ Detectar fallas en manipulación e higiene
- aureus es un indicador directo de contaminación humana.
✅ Prevenir brotes por enterotoxinas
La detección temprana evita intoxicaciones de alto impacto mediático.
✅ Asegurar calidad y vida útil
Control preventivo en productos sometidos a manipulación post-proceso.
✅ Cumplir auditorías internacionales
Un método universalmente aceptado por certificaciones HACCP, FSSC 22000 y regulaciones de exportación.

✅ Conclusión El Agar Baird-Parker, en el marco de la ISO 6888, representa un pilar esencial en los programas de control microbiológico de alimentos. Su elevada selectividad, capacidad diferencial y amplio respaldo científico lo convierten en el medio más confiable para el aislamiento presuntivo de Staphylococcus aureus. Al adoptar este método, los laboratorios no solo cumplen con un estándar técnico, sino que fortalecen la prevención, protegen la salud del consumidor y garantizan la integridad de toda la cadena de producción.

